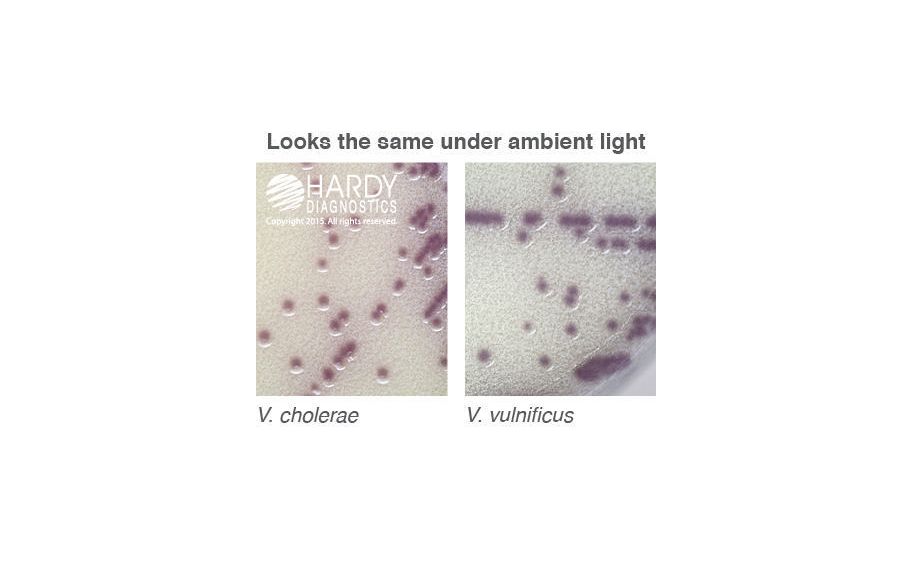
main product photo

Need Help?
800-229-7252

CULTURE MEDIA DEHYDRATED HARDYCHROM 2 L.
1
/
EA
Lead Time
12 Day(s)
SKU
VWR75832-742-EA
MFRPN
C9010
CULTURE MEDIA DEHYDRATED HARDYCHROM 2 L.
HardyCHROM* Dehydrated Culture Media 2L HardyCHROM* Vibrio, CRITERION* Dehydrated Culture Media, Mylar* zip-pouch, Vibrio is perfect for environmental testing, Wide mouth opening - reduces dust formation by allowing the easy entry of a scoop, Stackable containers - for efficient storage, Size: 2L
| Manufacturer | Hardy Diagnostics |
|---|---|
| MFRPN | C9010 |
| Lead Time | 12 Day(s) |
| UNSPSC Code | 42000000 |
Write Your Own Review